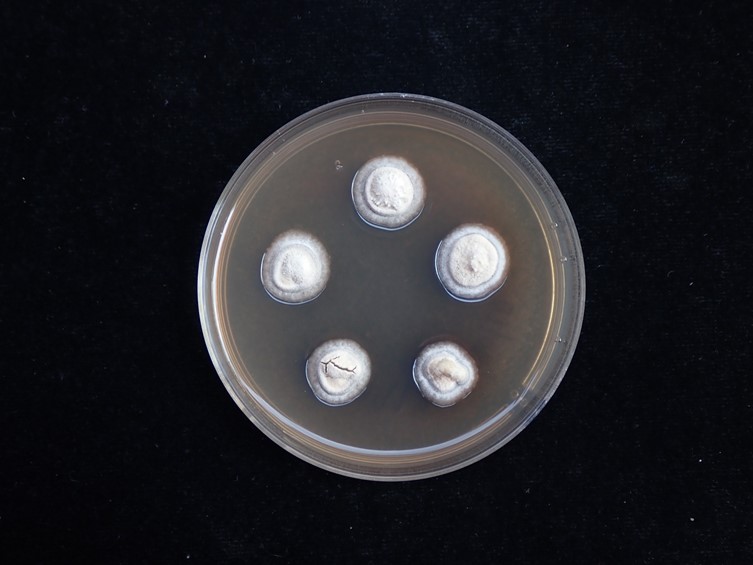

Habitat:
Buried in soil.
Host:
On Tenebrionidae.
Description:
 Stromata multiple, clavate, pale yellow, arising from head, thorax and abdomen of Tenebrionidae larvae (Coleoptera), 2–10 mm long. Stipes cylindrical, smooth, pale yellow, 0.5–1.5 mm wide. Ascomata formed on upper part of the stipe, or subterminal, occasionally located on one side of the stipe, pale yellow, densely packed
Stromata multiple, clavate, pale yellow, arising from head, thorax and abdomen of Tenebrionidae larvae (Coleoptera), 2–10 mm long. Stipes cylindrical, smooth, pale yellow, 0.5–1.5 mm wide. Ascomata formed on upper part of the stipe, or subterminal, occasionally located on one side of the stipe, pale yellow, densely packed  perithecia, 2–4 mm long, 1.5–2 mm wide. Perithecia immersed, tightly packed, broad ovoid, 400–500 × 250–350 μm.
perithecia, 2–4 mm long, 1.5–2 mm wide. Perithecia immersed, tightly packed, broad ovoid, 400–500 × 250–350 μm.  Asci cylindrical, 200–300 μm long, 6–8 μm wide with asci caps 3.5–7 × 3.5–8 μm.
Asci cylindrical, 200–300 μm long, 6–8 μm wide with asci caps 3.5–7 × 3.5–8 μm.  Ascospores cylindrical, 200–250 μm long, breaking into 32 small truncate part-spores, 5–10 × 1.5–3 μm.
Ascospores cylindrical, 200–250 μm long, breaking into 32 small truncate part-spores, 5–10 × 1.5–3 μm.
Culture characteristics:
Colonies on PDA attaining a diam of 12–15 mm in 30 d, white, colonies reverse greyish brown.
Colonies on PDA attaining a diam of 12–15 mm in 30 d, white, colonies reverse greyish brown.  Conidiogenous cells monophialidic, cylindrical basal portion with acute end, 5–15 × 1–3 μm.
Conidiogenous cells monophialidic, cylindrical basal portion with acute end, 5–15 × 1–3 μm.  Conidia hyaline, smooth-walled, cylindrical, 5–10 × 1.5–3 μm, not aggregated in slimy heads at the apex phialides.
Conidia hyaline, smooth-walled, cylindrical, 5–10 × 1.5–3 μm, not aggregated in slimy heads at the apex phialides.
Reference:
Mongkolsamrit S, Noisripoom W, Tasanathai K, et al. (2024). Uncovering cryptic species diversity of Ophiocordyceps (Ophiocordycipitaceae) associated with Coleoptera from Thailand. Fungal Systematics and Evolution14: 223–250.
DOI: https://doi:10.3114/fuse.2024.14.15Species |
Strain |
Compound |
Pubchem CID |
Biological activity |
Reference |
|---|
|
Strain |
|---|